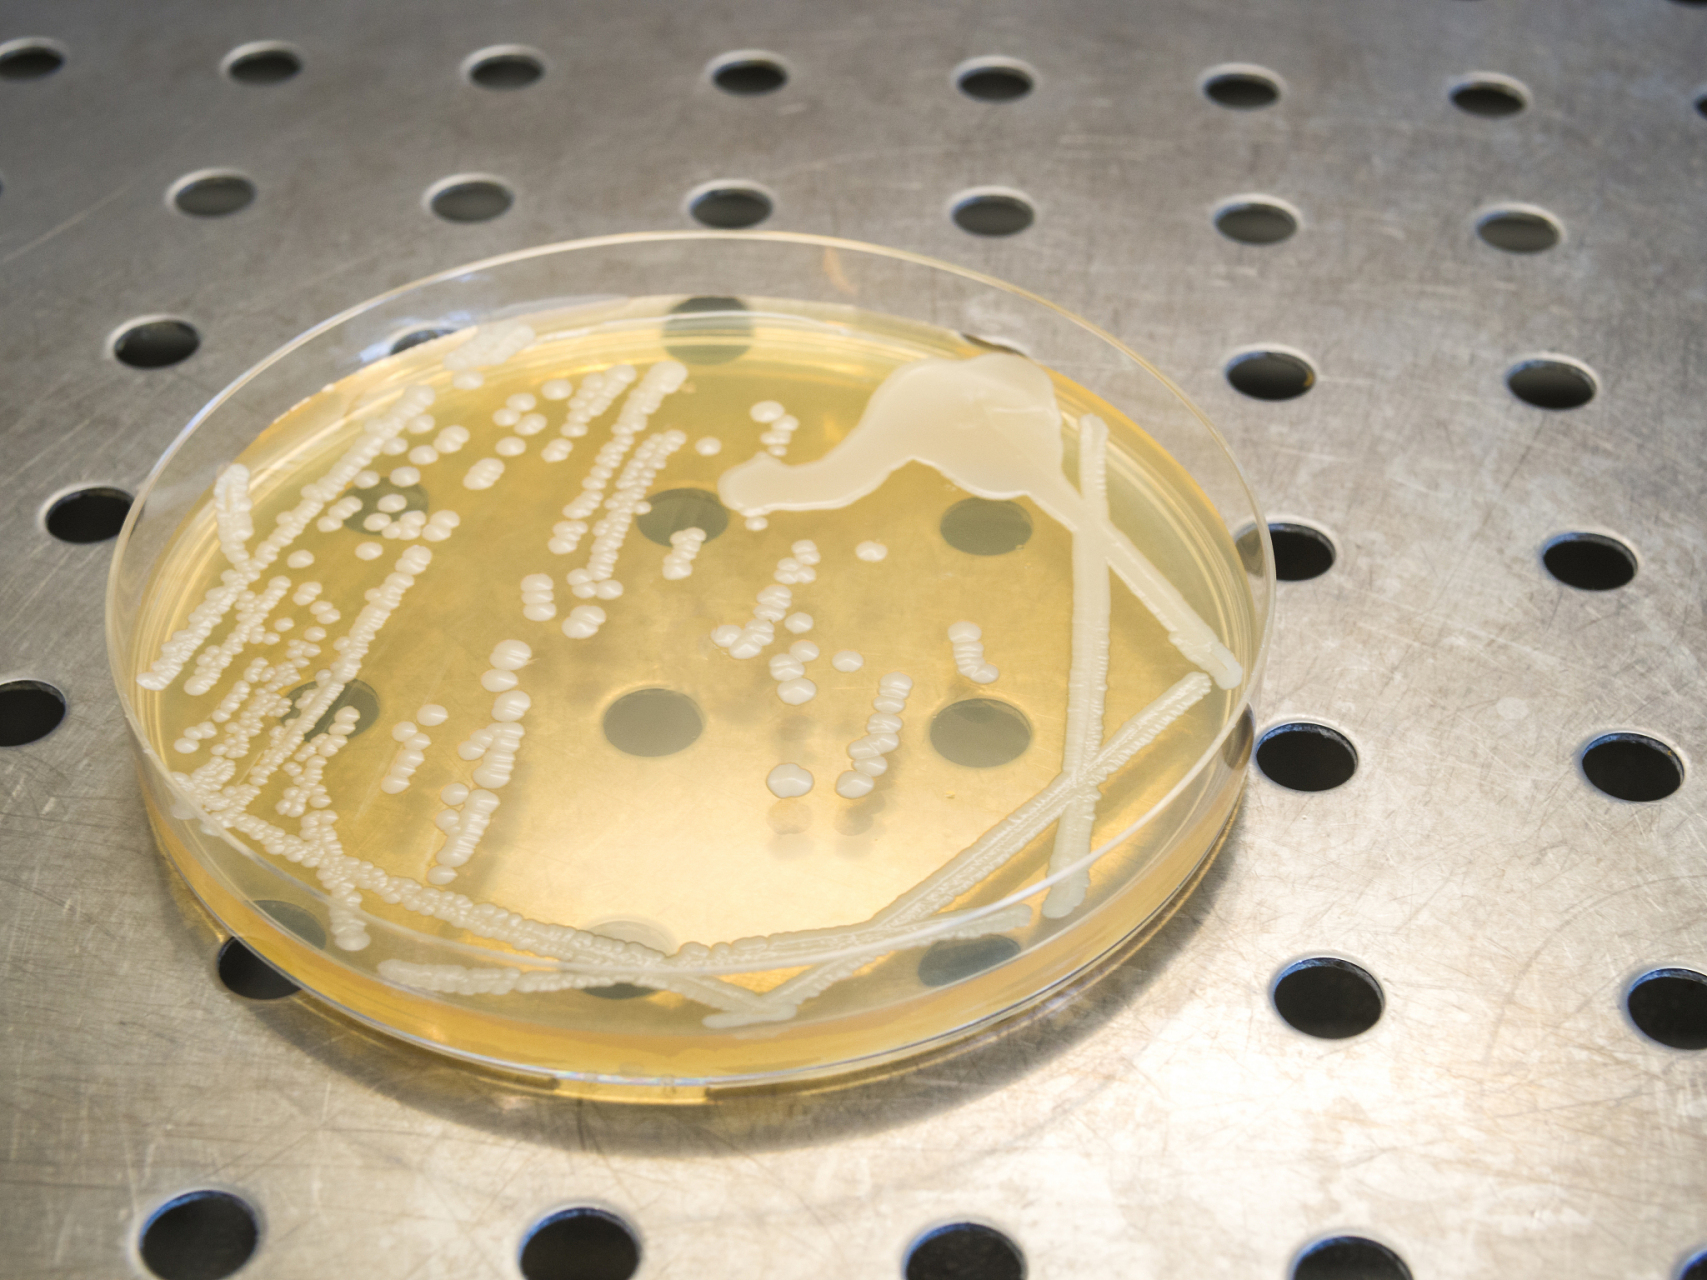
抑菌实验用于测定抗菌药物体外抑制细菌生长的效力,包括药物贮存液
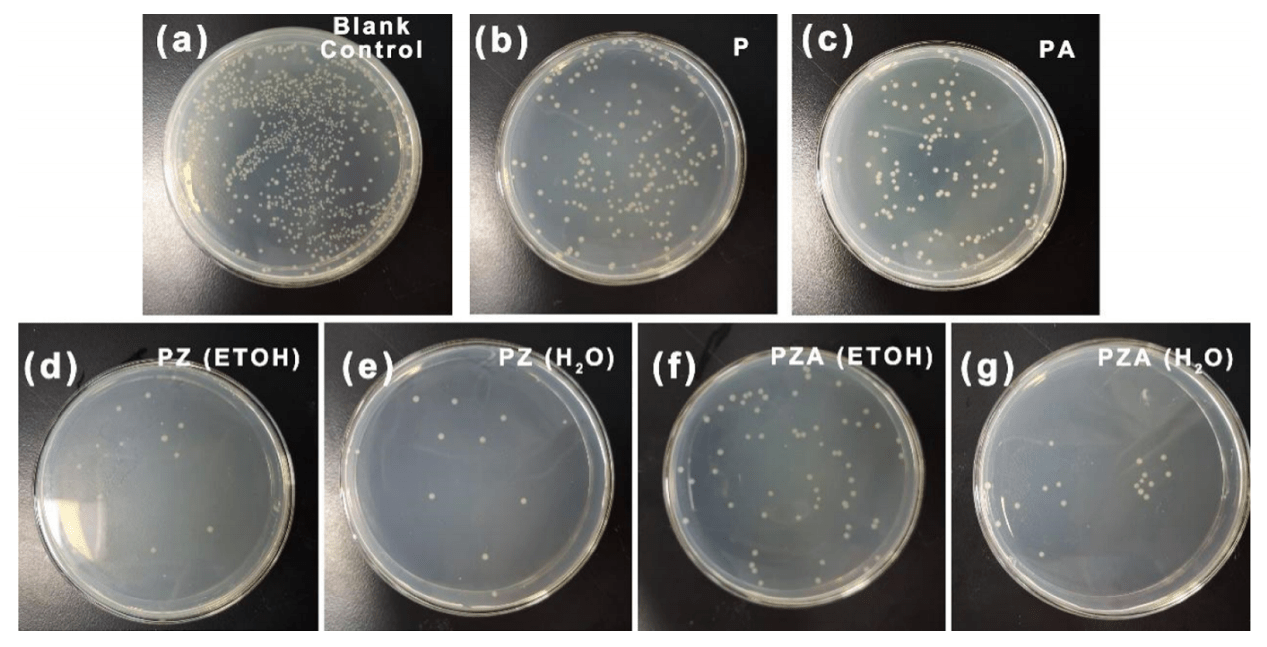
兼具红外隐身,自清洁及抗菌功能的pan/al–zno/ag纳
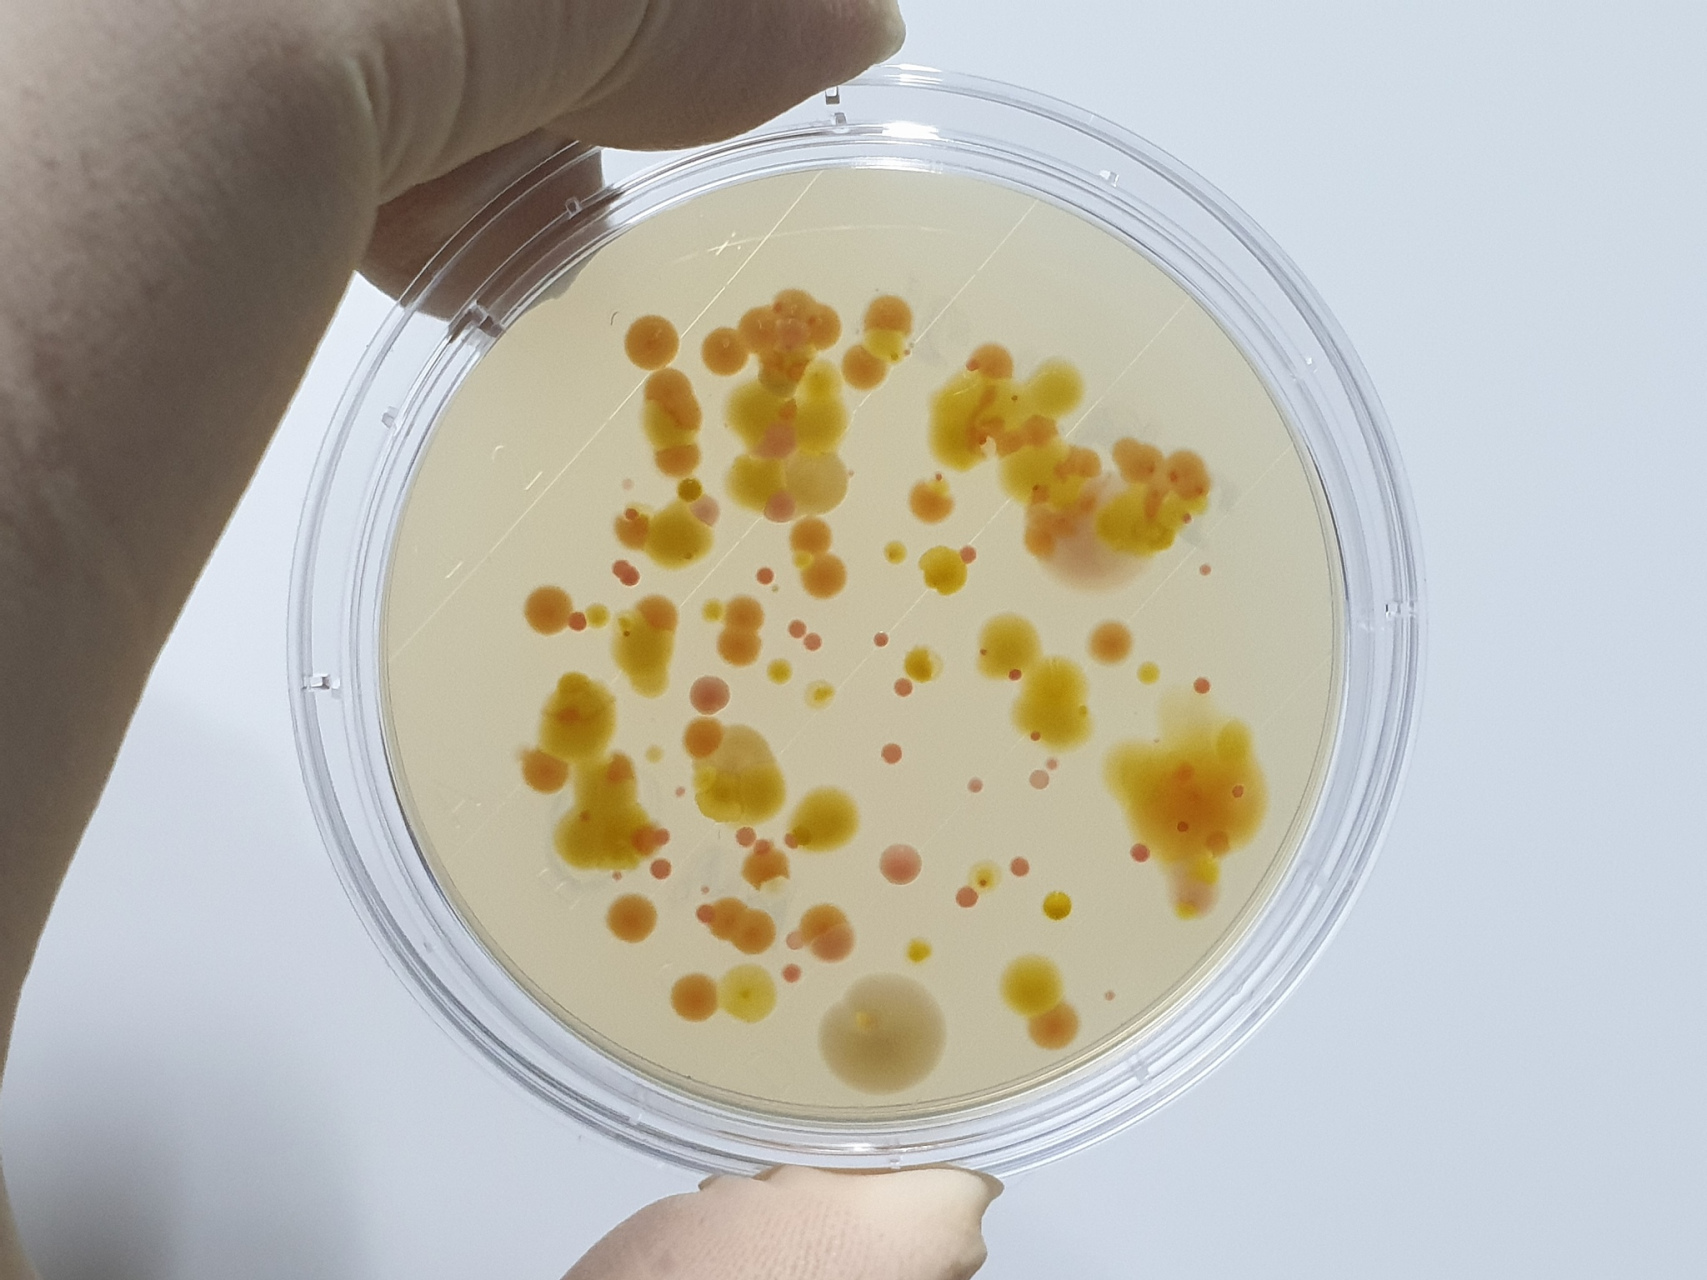
抑菌实验用于测定抗菌药物体外抑制细菌生长的效力,包括药物贮存液

抑菌实验图片

抑菌圈实验-孤独の吡哆醛-抗菌实验-哔哩哔哩视频
图片尺寸1728x1080
牛津杯抑菌实验
图片尺寸339x360
抑菌环试验
图片尺寸323x240
抑菌实验用于测定抗菌药物体外抑制细菌生长的效力,包括药物贮存液
图片尺寸1707x1280
通过抑菌实验,可以测定一个药物的最低抑菌浓度,用以评价该药物的抑菌
图片尺寸639x433
抑菌圈
图片尺寸2667x2000
打孔法测抑菌圈实验
图片尺寸1728x1080
塑料为什么要做抗菌检测?塑料抗菌检测的方法有哪些?
图片尺寸600x400
抑菌试验
图片尺寸500x375
抑菌试验求助 - 微生物 - 实验/技术 - 小木虫论坛-学术科研互动平台
图片尺寸750x750
兼具红外隐身,自清洁及抗菌功能的pan/al–zno/ag纳
图片尺寸1267x647
【求助】急~~做抑菌试验没有出现抑菌圈的原因
图片尺寸3872x2592
抑菌剂效力检测-温州维科生物实验设备有限公司
图片尺寸1998x1406
抑菌试验技术服务是一种用于测定抗菌药物体外抑制细菌生长效力的实验
图片尺寸5400x3600
抑菌实验用于测定抗菌药物体外抑制细菌生长的效力,包括药物贮存液
图片尺寸1707x1280
【实验】平板抑菌实验2:菌液纯化,打孔法
图片尺寸672x378
伊莱特抗菌实验河南省畜牧研究所图
图片尺寸1124x811
抗菌实验—抑菌圈法_第2页
图片尺寸920x1302
最小抑菌浓度(mic)试验/药敏试验
图片尺寸500x333
抑菌圈试验
图片尺寸590x331